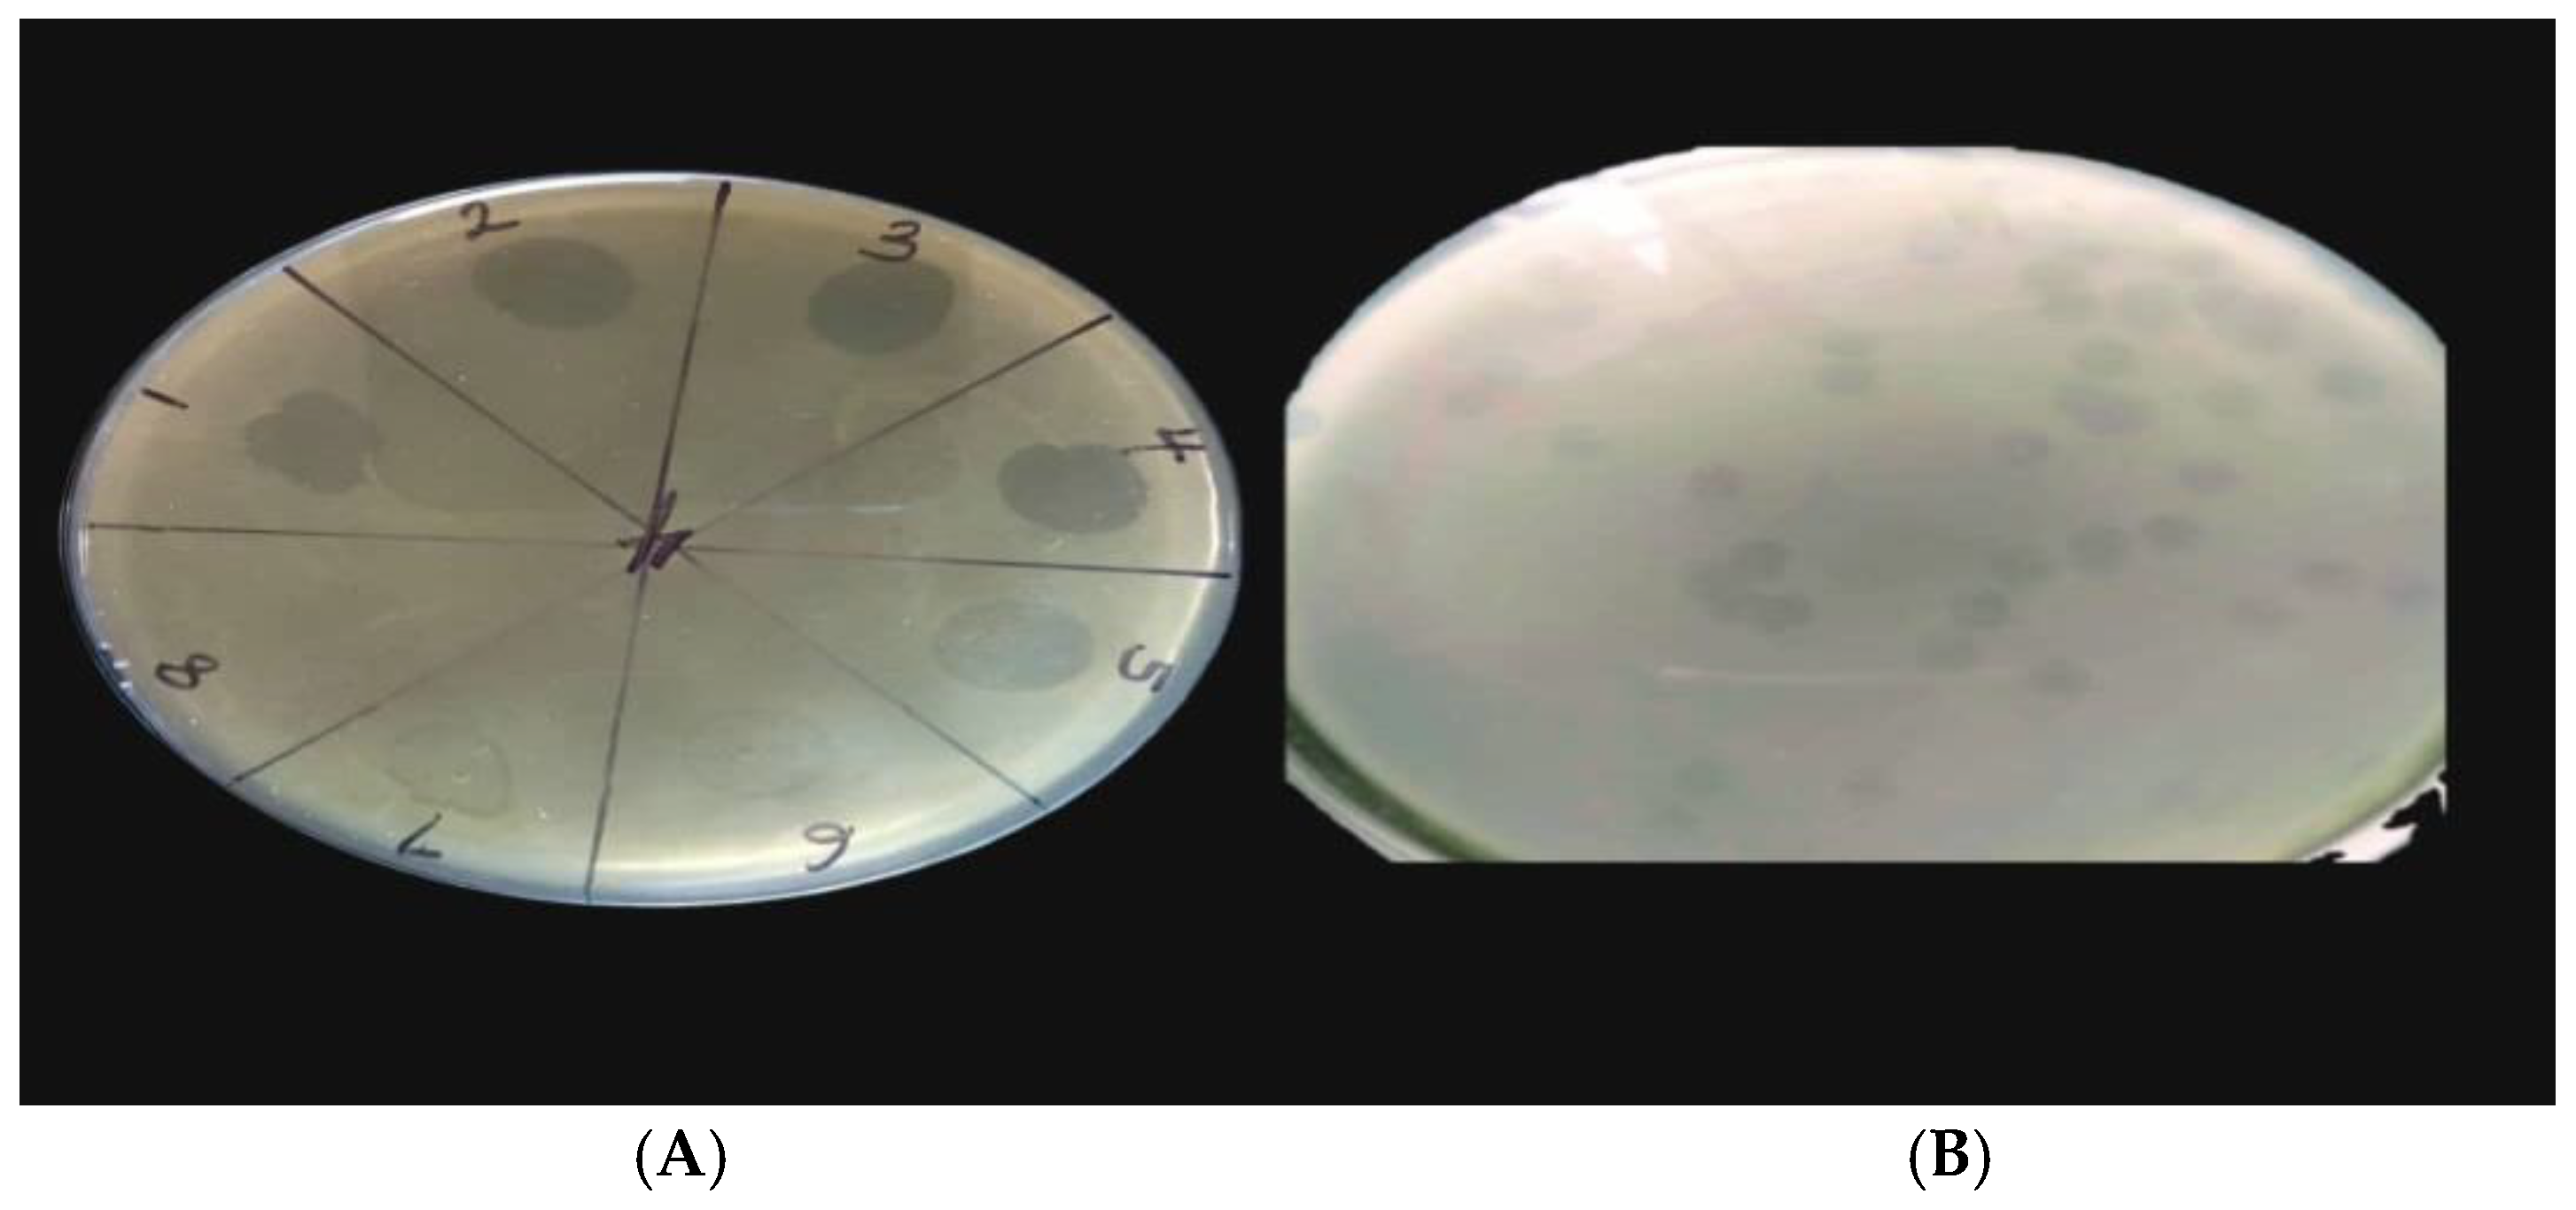
Antibiotics 13 01006 g001

Isolation and Characterization of a Novel Jumbo Phage HPP-Temi Infecting Pseudomonas aeruginosa Pa9 and Increasing Host Sensitivity to Ciprofloxacin
Abstract
:1. Introduction
2. Results
2.1. Isolation of Bacteriophages
2.2. Morphological Features
2.3. Phage Stability Under Different Chemical and Physical Conditions
2.4. Complete Genome Analysis
2.5. Genomic Similarity to Other Phages
2.6. Phage-Antibiotics Combination Against P. aeruginosa
3. Discussion
3.1. Virions of Pseudomonas Phage HPP-Temi
3.2. The Complete Genome of Pseudomonas Phage HPP-Temi
3.3. Genomic Similarity to Other Phages
3.4. HPP-Temi Improves Ciprofloxacin Efficacy
4. Materials and Methods
4.1. Bacterial Culture and Preparations and Sample Collection
4.2. Enrichment and Isolation of Bacteriophages
4.3. Preparation of Bacterial Lawn and Plaque Formation
4.4. Phage Titration and Purification
4.5. Host Range Determination
4.6. Transmission Electron Microscopy
4.7. Thermal, pH, and Salinity Stability
4.8. Phage DNA Extraction
4.9. Whole-Genome Sequencing
4.10. De Novo Assembly and Functional Annotation of HPP-Temi Genome
4.11. Determination of Relationship to Other Sequenced Phages
4.12. Shared Gene Content Analysis with the Most Closely Related Phages
4.13. Genome Packing Strategy Prediction for Proposed Pawisnkivirus Representatives
4.14. Phage Antibiotics Combination
5. Conclusions
6. Limitations
Supplementary Materials
Author Contributions
Funding
Institutional Review Board Statement
Informed Consent Statement
Data Availability Statement
Acknowledgments
Conflicts of Interest
References
- Hutchings, M.; Truman, A.; Wilkinson, B. Antibiotics: Past, present and future. Curr. Opin. Microbiol. 2019, 5, 72–80. [Google Scholar] [CrossRef] [PubMed]
- Prescott, J.F. The resistance tsunami, antimicrobial stewardship, and the golden age of microbiology. Vet. Microbiol. 2014, 171, 273–278. [Google Scholar] [CrossRef] [PubMed]
- O’Neill, J. Review on Antimicrobial Resistance: Tackling Drug-Resistant Infections Globally: Final Report and Recommendations. Centre for Agriculture and Bioscience International, 2019. Available online: https://www.cabdirect.org/globalhealth/abstract/20163354200 (accessed on 17 November 2021).
- Donkor, E.S.; Muhsen, K.; Johnson, S.A.M.; Kotey, F.C.N.; Dayie, N.T.K.D.; Tetteh-Quarcoo, P.B.; Tette, E.M.A.; Osei, M.M.; Egyir, B.; Nii-Trebi, N.I.; et al. Multicenter Surveillance of Antimicrobial Resistance among Gram-Negative Bacteria Isolated from Bloodstream Infections in Ghana. Antibiotics 2023, 12, 255. [Google Scholar] [CrossRef] [PubMed]
- Murray, C.J.; Ikuta, K.S.; Sharara, F.; Swetschinski, L.; Robles Aguilar, G.; Gray, A.; Han, C.; Bisignano, C.; Rao, P.; Wool, E.; et al. Global burden of bacterial antimicrobial resistance in 2019: A systematic analysis. Lancet 2022, 399, 629–655. [Google Scholar] [CrossRef] [PubMed]
- Kutateladze, M.; Adamia, R. Bacteriophages as potential new therapeutics to replace or supplement antibiotics. Trends Biotechnol. 2010, 28, 591–595. [Google Scholar] [CrossRef] [PubMed]
- Haddad Kashani, H.; Schmelcher, M.; Sabzalipoor, H.; Seyed Hosseini, E.; Moniri, R. Recombinant endolysins as potential therapeutics against antibiotic-resistant staphylococcus aureus: Current status of research and novel delivery strategies. Clin. Microbiol. Rev. 2018, 31, 10-1128. [Google Scholar] [CrossRef]
- Bruttin, A.; Brussow, H. Human volunteers receiving Escherichia coli phage T4 orally: A safety test of phage therapy. Antimicrob. Agents Chemother. 2005, 49, 2874–2878. [Google Scholar] [CrossRef]
- Marza, J.A.S.; Soothill, J.S.; Boydell, P.; Collyns, T.A. Multiplication of therapeutically administered bacteriophages in Pseudomonas aeruginosa infected patients. Burns 2006, 32, 644–646. [Google Scholar] [CrossRef]
- Gao, D.; Ji, H.; Wang, L.; Li, X.; Hu, D.; Zhao, J.; Wang, S.; Tao, P.; Li, X.; Qian, P. Fitness Trade-Offs in Phage Cocktail-Resistant Salmonella enterica Serovar Enteritidis Results in Increased Antibiotic Susceptibility and Reduced Virulence. Microbiol. Spectr. 2002, 10, e02914-22. [Google Scholar] [CrossRef]
- León, M.; Bastías, R. Virulence reduction in bacteriophage resistant bacteria. Front. Microbiol. 2015, 6, 343. [Google Scholar] [CrossRef]
- Abendon, S.T.; Garcia, P.; Mullany, P.; Aminov, R. Phage therapy: Past, Present and future. Front. Microbiol. 2017, 8, 981. [Google Scholar]
- Lin, D.M.; Kaoskella, B.; Lin, H.C. Phage therapy: An alternative to antibiotics in the age of multidrug resistance. World J. Gastrointest. Pharmacolol. Ther. 2017, 8, 162–173. [Google Scholar] [CrossRef] [PubMed]
- Pirnay, J.P.; Verbeken, G.; Rose, T.; Jennes, S.; Zizi, M.; Huys, I.; Merabishvili, M. Introducing Yesterday’s phage therapy in today’s medicine. Future Virol. 2015, 10, 377–390. [Google Scholar] [CrossRef]
- Chanishvili, N. Phage therapy—History from Twort and d’Herelle through Soviet experience to current approaches. Adv. Virus Res. 2012, 83, 3–40. [Google Scholar]
- Skurnik, M. Can Bacteriophages Replace Antibiotics? Antibiotics 2022, 11, 575. [Google Scholar] [CrossRef]
- Fedorov, E.; Samokhin, A.; Kozlova, Y.; Kretien, S.; Sheraliev, T.; Morozova, V.; Tikunova, N.; Kiselev, A.; Pavlov, V. Short-Term Outcomes of Phage-Antibiotic Combination Treatment in Adult Patients with Periprosthetic Hip Joint Infection. Viruses 2023, 15, 499. [Google Scholar] [CrossRef]
- Schooley, R.T.; Biswas, B.; Gill, J.J.; Hernandez-Morales, A.; Lancaster, J.; Lessor, L.; Barr, J.J.; Reed, S.L.; Rohwer, F.; Benler, S.; et al. Development and use of personalized bacteriophage-based therapeutic cocktails to treat a patient with a disseminated resistant Acinetobacter baumannii infection. Antimicrob. Agents Chemother. 2017, 61, 10-1128. [Google Scholar] [CrossRef]
- Osman, A.H.; Kotey, F.C.N.; Odoom, A.; Darkwah, S.; Yeboah, R.K.; Dayie, N.T.K.D.; Donkor, E.S. The Potential of Bacteriophage-Antibiotic Combination Therapy in Treating Infections with Multidrug-Resistant Bacteria. Antibiotics 2023, 12, 1329. [Google Scholar] [CrossRef]
- D’Agata, E. Pseudomonas aeruginosa and other Pseudomonas species. In Mandell, Douglas, and Bennett’s Principles and Practice of Infectious Diseases, 8th ed.; Bennett, J.E., Dolin, R., Blaser, M.J., Eds.; Saunders: Philadelphia, PA, USA, 2015; pp. 2518–2531. [Google Scholar]
- Morita, Y.; Tomida, J.; Kawamura, Y. Responses of Pseudomonas aeruginosa to antimicrobials. Front. Microbiol. 2014, 4, 422. [Google Scholar] [CrossRef]
- Van Nieuwenhuyse, B.; Van der Linden, D.; Chatzis, O.; Lood, C.; Wagemans, J.; Lavigne, R.; Schroven, K.; Paeshuyse, J.; de Magnée, C.; Sokal, E.; et al. Bacteriophage-antibiotic combination therapy against extensively drug-resistant Pseudomonas aeruginosa infection to allow liver transplantation in a toddler. Nat. Commun. 2022, 13, 5725. [Google Scholar] [CrossRef] [PubMed] [PubMed Central]
- Kalil, A.C.; Metersky, M.L.; Klopas, M.; Brozek, J.L. Management of Adults with Hospital Acquired and Ventilator-associated Pneumonia Clinical Practice Guidelines by the Infectious Diseases Society of America and American Thoracic Society. Clin. Infect. Dis. 2016, 63, e61–e111. [Google Scholar] [CrossRef] [PubMed]
- Thaden, J.T.; Park, L.P.; Maskarinec, S.A.; Duin, D. Result from 13year prospective cohort study shoe increase mortality associated with bloodstream infection caused by Pseudomonas aeruginosa compared to other bacteria. Antimicrob. Agent Chemother. 2017, 61, 10-1128. [Google Scholar] [CrossRef] [PubMed]
- Matos, E.C.O.D.; Andriolo, R.B.; Rodrigues, Y.C.; Lima, P.D.L.D.; Carneiro, I.C.; Lima, K.V. Mortality in patients with multidrug resistant Pseudomonas aeruginosa infections: A meta-analysis. Rev. Da Soc. Bras. De Med. Trop. 2018, 51, 415–420. [Google Scholar] [CrossRef] [PubMed]
- De Oliveira, D.M.P.; Forde, B.M.; Kidd, T.J.; Harris, P.N.A.; Schembri, M.A.; Beatson, S.A.; Paterson, D.L.; Walker, M.J. Antimicrobial Resistance in ESKAPE Pathogens. Clin. Microbiol. Rev. 2020, 33, 10-1128. [Google Scholar] [CrossRef]
- Bitsori, M.; Maraki, S.; Koukouraki, S.; Galanakis, E. Pseudomonas aeruginosa urinary tract infection in children: Risk factors and outcomes. J. Urol. 2012, 187, 260–264. [Google Scholar] [CrossRef]
- Nielsen, S.L.; Lassen, A.T.; Gradel, K.O.; Jensen, T.G.; Kolmos, H.J.; Hallas, J.; Pedersen, C. Bacteremia is associated with excess long-term mortality: A 12-year population-based cohort study. J. Infect. 2015, 70, 111–126. [Google Scholar] [CrossRef]
- Winstanley, C.; O’Brien, S.; Brockhurst, M.A. Pseudomonas aeruginosa Evolutionary Adaptation and Diversification in Cystic Fibrosis Chronic Lung Infections. Trends Microbiol. 2016, 24, 327–337. [Google Scholar] [CrossRef]
- Pachori, P.; Gothalwal, R.; Gandhi, P. Emergence of antibiotic resistance Pseudomonas aeruginosa in intensive care unit; A critical review. Genes Dis. 2019, 6, 109–119. [Google Scholar] [CrossRef]
- Kellenberger, G.; Kellenberger, E. Electron microscopical studies of phage multiplication. III. Observation of single cell bursts. Virology 1957, 3, 275–285. [Google Scholar] [CrossRef]
- Wood, S.J.; Kuzel, T.M.; Shafikhani, S.H. Pseudomonas aeruginosa: Infections, Animal Modeling, and Therapeutics. Cells 2023, 12, 199. [Google Scholar] [CrossRef]
- Imklin, N.; Nasanit, R. Characterization of Salmonella bacteriophages and their potential use in dishwashing materials. J. Appl. Microbiol. 2020, 129, 266–277. [Google Scholar] [CrossRef] [PubMed]
- Manohar, P.; Loh, B.; Nachimuthu, R.; Leptihn, S. Phage-antibiotics combination to control Pseudomonas aeruginosa–candida two-species biofilm. Sci. Rep. 2024, 14, 9354. [Google Scholar] [CrossRef] [PubMed]
- Krylov, V.; Bourkaltseva, M.; Pleteneva, E.; Shaburova, O.; Krylov, S.; Karaulov, A.; Zhavoronok, S.; Svitich, O.; Zverev, V. Phage phiKZ-The First of Giants. Viruses 2021, 13, 149. [Google Scholar] [CrossRef] [PubMed]
- Abdelsattar, A.S.; Safwat, A.; Nofal, R.; Elsayed, A.; Makky, S.; El-Shibiny, A. Isolation and characterization of Bacteriophage ZCSE6 against Salmonella spp.: Phage application in Milk. Biologics 2021, 1, 164–176. [Google Scholar] [CrossRef]
- Sun, Z.M.; Wen, H.; Ma, L.; Chen, Z. Isolation characterization and application of bacteriophage PSDA-2 against Salmonella typhimurium in chilled mutton. PLoS ONE 2022, 17, e0262946. [Google Scholar] [CrossRef]
- Sharma, S.; Datta, S.; Chatterjee, S.; Dutta, M.; Samanta, J.; Vairale, M.G.; Gupta, R.; Veer, V.; Dwivedi, S.K. Isolation and characterization of a lytic bacteriophage against Pseudomonas aeruginosa. Sci. Rep. 2021, 11, 19393. [Google Scholar] [CrossRef]
- Merrill, B.D.; Ward, A.T.; Grose, J.H.; Hope, S. Software-Based Analysis of Bacteriophage Genomes, Physical Ends, and Packaging Strategies. BMC Genom. 2016, 17, 679. [Google Scholar] [CrossRef]
- Abedon, S.T.; Kuhl, S.J.; Blasdel, B.G.; Kutter, E.M. Phage treatment of human infections. Bacteriophage 2011, 1, 66–85. [Google Scholar] [CrossRef]
- Chang, R.; Das, T.; Manos, J.; Kutter, E.Y.; Morales, S.; Chan, H.K. Bacteriophage PEV20 and ciprofloxacin combination treatment enhances the removal of Pseudomonas aeruginosa biofilm isolated from cystic fibrosis and wound patients. AAPS J. 2019, 21, 49. [Google Scholar] [CrossRef]
- Chan, B.K.; Sistrom, M.; Wertz, J.E.; Kortright, K.E.; Narayan, D.; Turner, P.E. Phage selection restores antibiotic sensitivity in MDR Pseudomonas aeruginosa. Sci. Rep. 2016, 6, 26717. [Google Scholar] [CrossRef]
- Edgar, R.; Friedman, N.; Molshanski-Mor, S.; Qimron, U. Reversing bacterial resistance to antibiotics by phage-mediated delivery of dominant sensitive genes. Appl. Environ. Microbiol. 2012, 78, 744–751. [Google Scholar] [CrossRef] [PubMed]
- Xuan, G.; Lin, H.; Kong, J.; Wang, J. Phage resistance evolution induces the sensitivity of specific antibiotics in Pseudomonas aeruginosa PAO1. Microbiol. Spectr. 2022, 10, e01356-22. [Google Scholar] [CrossRef] [PubMed]
- Masoumeh, H.Z.; Ali, M.; Nour, A.; Vahid, P.M. Characterizing a Lytic Bacteriophage Infecting Methicillin-Resistant Staphylococcus aureus (MRSA) Isolated from Burn Patients. Clin. Infect. Dis. 2020, 5, e91634. [Google Scholar] [CrossRef]
- Ateba, C.N.; Akindolire, M.A. Isolation and Characterization of Bacteriophages with Lytic Activity Against Virulent Escherichia coli O157:H7: Potential Bio-Control Agents. Preprints 2019, 2019010132. [Google Scholar] [CrossRef]
- Aguilera, M.; Martinez, S.; Tello, M.; Gallardo, M.J.; Garcia, V. Use of Cocktail of Bacteriophage for Salmonella typhimurium control in chicken meat. Foods 2022, 11, 1164. [Google Scholar] [CrossRef]
- Imklin, N.; Chaengphaniad, P.; Simoliunas, E.; Nasanit, R. A novel Stapylococcus phage, vB_Sau-RP15, and its Application in contaminated milk. Lett. Appl. Microbiol. 2022, 76, ovac003. [Google Scholar] [CrossRef]
- Zrelovs, N.; Jansons, J.; Kazaka, T.; Kazaks, A.; Dislers, A. Three Phages One Host: Isolation and Characterization of Pantoea agglomerans Phages from a Grasshopper Specimen. Int. J. Mol. Sci. 2023, 24, 1820. [Google Scholar] [CrossRef]
- Schneider, C.A.; Rasband, W.S.; Eliceiri, K.W. NIH Image to ImageJ: 25 Years of Image Analysis. Nat. Methods 2012, 9, 671–675. [Google Scholar] [CrossRef]
- Andrews, S. FastQC—A Quality Control Tool for High Throughput Sequence Data. Available online: https://www.bioinformatics.babraham.ac.uk/projects/fastqc/ (accessed on 17 November 2021).
- Bushnell, B. BBMap: A Fast, Accurate, Splice-Aware Aligner. In Proceedings of the Conference 9th Annual Genomics of Energy & Environment Meeting, Walnut Creek, CA, USA, 17–20 March 2014. [Google Scholar]
- Wick, R.R.; Judd, L.M.; Gorrie, C.L.; Holt, K.E. Unicycler: Resolving Bacterial Genome Assemblies from Short and Long Sequencing Reads. PLoS Comput. Biol. 2017, 13, e1005595. [Google Scholar] [CrossRef]
- Garneau, J.R.; Depardieu, F.; Fortier, L.C.; Bikard, D.; Monot, M. PhageTerm: A Tool for Fast and Accurate Determination of Phage Termini and Packaging Mechanism Using Next-Generation Sequencing Data. Sci. Rep. 2017, 7, 8292. [Google Scholar] [CrossRef]
- Li, H.; Durbin, R. Fast and Accurate Short Read Alignment with Burrows-Wheeler Transform. Bioinformatics 2009, 25, 1754–1760. [Google Scholar] [CrossRef] [PubMed]
- Bouras, G.; Nepal, R.; Houtak, G.; Psaltis, A.J.; Wormald, P.-J.; Vreugde, S. Pharokka: A Fast Scalable Bacteriophage Annotation Tool. Bioinformatics 2023, 39, btac776. [Google Scholar] [CrossRef] [PubMed]
- McNair, K.; Zhou, C.; Dinsdale, E.A.; Souza, B.; Edwards, R.A. PHANOTATE: A Novel Approach to Gene Identification in Phage Genomes. Bioinformatics 2019, 35, 4537–4542. [Google Scholar] [CrossRef] [PubMed]
- Laslett, D.; Canback, B. ARAGORN, a Program to Detect tRNA Genes and tmRNA Genes in Nucleotide Sequences. Nucleic Acids Res. 2004, 32, 11–16. [Google Scholar] [CrossRef] [PubMed]
- Lowe, T.M.; Eddy, S.R. tRNAscan-SE: A Program for Improved Detection of Transfer RNA Genes in Genomic Sequence. Nucleic Acids Res. 1997, 25, 955–964. [Google Scholar] [CrossRef] [PubMed]
- Alcock, B.P.; Raphenya, A.R.; Lau, T.T.Y.; Tsang, K.K.; Bouchard, M.; Edalatmand, A.; Huynh, W.; Nguyen, A.-L.V.; Cheng, A.A.; Liu, S.; et al. CARD 2020: Antibiotic Resistome Surveillance with the Comprehensive Antibiotic Resistance Database. Nucleic Acids Res. 2020, 48, D517–D525. [Google Scholar] [CrossRef]
- Chen, L.; Yang, J.; Yu, J.; Yao, Z.; Sun, L.; Shen, Y.; Jin, Q. VFDB: A Reference Database for Bacterial Virulence Factors. Nucleic Acids Res. 2005, 33, D325–D328. [Google Scholar] [CrossRef]
- Shimoyama, Y. pyCirclize: Circular Visualization in Python. 2022. Available online: https://moshi4.github.io/pyCirclize/ (accessed on 10 July 2024).
- Altschul, S.F.; Gish, W.; Miller, W.; Myers, E.W.; Lipman, D.J. Basic Local Alignment Search Tool. J. Mol. Biol. 1990, 215, 403–410. [Google Scholar] [CrossRef]
- Moraru, C.; Varsani, A.; Kropinski, A.M. VIRIDIC—A Novel Tool to Calculate the Intergenomic Similarities of Prokaryote-Infecting Viruses. Viruses 2020, 12, 1268. [Google Scholar] [CrossRef]
- Paradis, E.; Schliep, K. Ape 5.0: An Environment for Modern Phylogenetics and Evolutionary Analyses in R. Bioinformatics 2019, 35, 526–528. [Google Scholar] [CrossRef]
- Page, A.J.; Cummins, C.A.; Hunt, M.; Wong, V.K.; Reuter, S.; Holden, M.T.G.; Fookes, M.; Falush, D.; Keane, J.A.; Parkhill, J. Roary: Rapid Large-Scale Prokaryote Pan Genome Analysis. Bioinformatics 2015, 31, 3691–3693. [Google Scholar] [CrossRef] [PubMed]
- Conway, J.R.; Lex, A.; Gehlenborg, N. UpSetR: An R Package for the Visualization of Intersecting Sets and Their Properties. Bioinformatics 2017, 33, 2938–2940. [Google Scholar] [CrossRef] [PubMed]
- Katoh, K.; Standley, D.M. MAFFT Multiple Sequence Alignment Software Version 7: Improvements in Performance and Usability. Mol. Biol. Evol. 2013, 30, 772–780. [Google Scholar] [CrossRef] [PubMed]
- Kumar, S.; Stecher, G.; Tamura, K. MEGA7: Molecular Evolutionary Genetics Analysis Version 7.0 for Bigger Datasets. Mol. Biol. Evol. 2016, 33, 1870–1874. [Google Scholar] [CrossRef]
- Saitou, N.; Nei, M. The Neighbor-Joining Method: A New Method for Reconstructing Phylogenetic Trees. Mol. Biol. Evol. 1987, 4, 406–425. [Google Scholar] [CrossRef] [PubMed]
- Felsenstein, J. Confidence limits on phylogenies: An approach using the bootstrap. Evol. Int. J. Org. Evol. 1985, 39, 783–791. [Google Scholar] [CrossRef]
- Clinical and Laboratory Standards Institute. CLSI Performance Standard for Antimicrobial Susceptibility Testing, 30th ed.; CLSI Supplement M100; Clinical and Laboratory Standards Institute: Wayne, PA, USA, 2020; ISBN 978-1-68440-066-9. [Google Scholar]

| Accession | Phage | Genome Length (bp) | GC Content (%) | Submission CDS Count | Reannotated CDS Count | Hypothetical Proteins (%) | tRNAs | Species | Submitting Country | Collection Date | Isolation Source |
|---|---|---|---|---|---|---|---|---|---|---|---|
| PP968062.1 | Pseudomonas phage HPP-Temi | 302,719 | 46.46% | 436 | 436 | 77.06% | 7 | Proposed as sp. nov. | Nigeria | 25 September 2023 | Household sewage |
| NC_070882.1 | Pseudomonas phage vB_PaeM_PS119XW | 301,543 | 43.62% | 389 | 424 | 77.83% | 7 | Pawinskivirus PS119XW | Poland | Unknown | unknown |
| LC765218.1 | Pseudomonas phage BRkr | 306,291 | 43.47% | 391 | 429 | 77.62% | 7 | Pawinskivirus PS119XW * | Japan | 21 July 2022 | Wastewater |
| MK599315.1 | Pseudomonas phage PA1C | 304,671 | 43.63% | 401 | 447 | 77.63% | 8 | Pawinskivirus PS119XW * | Russia | Unknown | unknown |
| OU343167.1 | Pseudomonas phage vB_PaeM_phiLBG22 | 302,555 | 43.60% | 0 | 432 | 77.78% | 7 | Pawinskivirus PS119XW * | France | Unknown | unknown |
Disclaimer/Publisher’s Note: The statements, opinions and data contained in all publications are solely those of the individual author(s) and contributor(s) and not of MDPI and/or the editor(s). MDPI and/or the editor(s) disclaim responsibility for any injury to people or property resulting from any ideas, methods, instructions or products referred to in the content. |
© 2024 by the authors. Licensee MDPI, Basel, Switzerland. This article is an open access article distributed under the terms and conditions of the Creative Commons Attribution (CC BY) license (https://creativecommons.org/licenses/by/4.0/).
Share and Cite
Olorundare, O.O.; Zrelovs, N.; Kabantiyok, D.; Svanberga, K.; Jansons, J.; Kazaks, A.; Agada, G.O.; Agu, C.G.; Morenikeji, O.R.; Oluwapelumi, O.A.; et al. Isolation and Characterization of a Novel Jumbo Phage HPP-Temi Infecting Pseudomonas aeruginosa Pa9 and Increasing Host Sensitivity to Ciprofloxacin. Antibiotics 2024, 13, 1006. https://doi.org/10.3390/antibiotics13111006
Olorundare OO, Zrelovs N, Kabantiyok D, Svanberga K, Jansons J, Kazaks A, Agada GO, Agu CG, Morenikeji OR, Oluwapelumi OA, et al. Isolation and Characterization of a Novel Jumbo Phage HPP-Temi Infecting Pseudomonas aeruginosa Pa9 and Increasing Host Sensitivity to Ciprofloxacin. Antibiotics. 2024; 13(11):1006. https://doi.org/10.3390/antibiotics13111006
Chicago/Turabian StyleOlorundare, Olufunke Olufunmilola, Nikita Zrelovs, Dennis Kabantiyok, Karina Svanberga, Juris Jansons, Andris Kazaks, Godwin Ojonugwa Agada, Chibuzor Gerald Agu, Oluwatoyin Ruth Morenikeji, Ogundeji Alice Oluwapelumi, and et al. 2024. "Isolation and Characterization of a Novel Jumbo Phage HPP-Temi Infecting Pseudomonas aeruginosa Pa9 and Increasing Host Sensitivity to Ciprofloxacin" Antibiotics 13, no. 11: 1006. https://doi.org/10.3390/antibiotics13111006
APA StyleOlorundare, O. O., Zrelovs, N., Kabantiyok, D., Svanberga, K., Jansons, J., Kazaks, A., Agada, G. O., Agu, C. G., Morenikeji, O. R., Oluwapelumi, O. A., Dung, T., & Pewan, S. B. (2024). Isolation and Characterization of a Novel Jumbo Phage HPP-Temi Infecting Pseudomonas aeruginosa Pa9 and Increasing Host Sensitivity to Ciprofloxacin. Antibiotics, 13(11), 1006. https://doi.org/10.3390/antibiotics13111006

